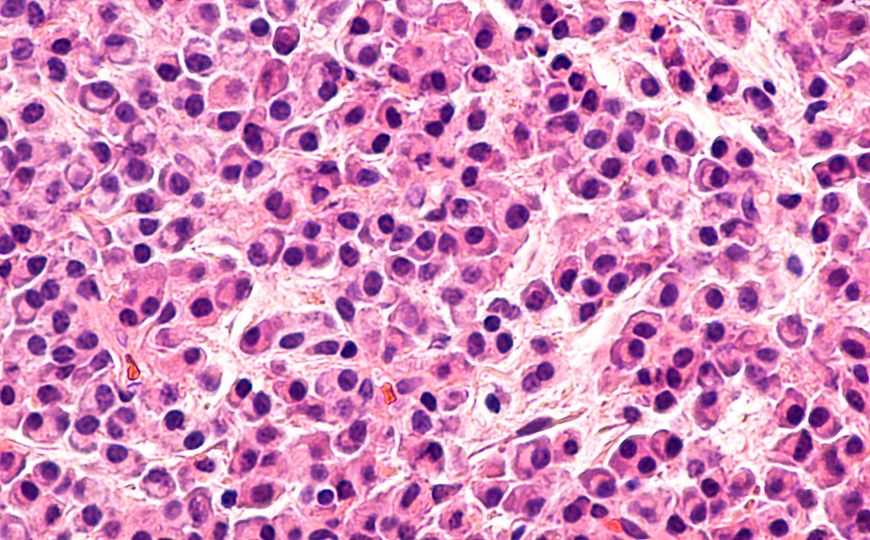

Тоцилизумаб успешно применили для лечения COVID-19 у пациента с множественной миеломой
Исследователи из Китая сообщают об успешном применении тоцилизумаба при лечении пациента с множественной миеломой и COVID-19 и предполагают, что эту терапию можно использовать при других видaх рака крови. Они также считают, что симптомы COVID-19 у таких пациентов могут отличаться от симптомов у людей без опухолей.
Тоцилизумаб, также известный как атлизумаб, — это рекомбинантное моноклональное антитело к человеческому рецептору интерлейкина-6 (ИЛ-6), которое используют в качестве иммуносупрессора при ряде заболеваний, например, при ревматоидном артрите.
Исследователи под руководством доктора Чанчэн Чжэна из Китайского университета науки и технологий предположили, что тоцилизумаб поможет нормализовать иммунный ответ при COVID-19 у пациентов с опухолевыми заболеваниями кроветвотворной и лимфатической ткани. «Такие пациенты находятся в состоянии иммунносупрессии, что в свою очередь может привести к повышенному риску COVID-19.
Каковы характеристики COVID-19 у пациентов с раком крови? Какие подходы оптимальны для их лечения? Мы ничего не знаем, и это послужило мотивацией к исследованию», — говорит доктор Чжэн.
Ученые проанализировали течение болезни у 60-летнего мужчины с множественной миеломой и COVID-19. Пациента госпитализировали с симптомами пневмонии и высоким уровнем провоспалительного цитокина ИЛ-6 в крови. Присутствие РНК SARS-COV-2 в мазках из носоглотки было подтверждено с помощью ПЦР с обратной транскрипцией. В 2015 у пациента была диагностирована множественная миелома, он получил 2 цикла химиотерапии бортезомибом, талидомидом и дексаметазоном, после чего симптомы заболевания исчезли, и пациент продолжал принимать талидомид в качестве поддерживающей терапии.
Известно, что при COVID-19 может происходить интенсивная секреция цитокинов, так называемый цитокиновый шторм. Ученые предположили, что в таком случае уместно применение тоцилизумаба. После однократного внутривенного введения тоцилизумаба концентрация ИЛ-6 в крови постепенно снизилась с 121,59 до 20,81 пг/мл, затем скачкообразно возросла до 317,38 пг/мл, после чего снова снизилась до 117,10 пг/мл. Такой пик уровня ИЛ-6 может свидетельствовать о нормализации работы Т-клеток. Через некоторое время пациент был выписан из больницы без симптомов COVID-19 или множественной миеломы.
Авторы отмечают, что симптомы, которые проявлялись у пациента, не были типичными для COVID-19. В частности, отсутствовал кашель и не повышалась температура тела. Ученые предполагают, что симптомы COVID-19 у людей со злокачественными опухолями лимфатической и кровеносной системы могут отличаться от симптомов большинства больных, однако нельзя сделать однозначный вывод на основе единичного случая.
В данной работе впервые показана эффективность тоцилизумаба для терапии коронавирусной инфекции у пациента с множественной миеломой. В марте 2020 года FDA одобрило проведение клинических испытаний тоцилизумаба в качестве терапии для взрослых пациентов с COVID-19.Источник
Цитата по пресс-релизу


 Меню
Меню





 Все темы
Все темы




 0
0












